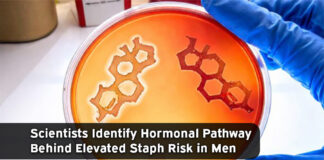

Close

We feature articles about leading professionals in the medical and healthcare industry in the South Texas area. We are your connection to the medical community!
Pick up a copy of our publication on more than 800 locations Valley-wide.
Subscribe